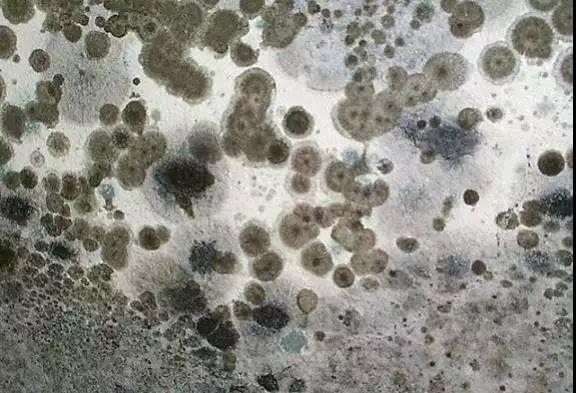

細菌等微生物在空氣中主要是含于飛沫中或附著于空氣顆粒上兩種形式存在,微生物會附于飛沫上或因飛沫蒸發(fā)形成“飛沫核”在空氣中漂浮。當飛沫或顆粒物距離墻面26mm左右時便會進入湍流邊界層,飛沫核和PM10就會在墻面上發(fā)生擴散沉積。
此外,細菌等有害微生物的生存條件需要水分、有機物和氧氣,且生存環(huán)境的酸堿度pH要求為3~8。而在正常的生活環(huán)境里,水分和氧氣是必不可少的,所以有效的方法是通過降低有機物含量來避免微生物的滋生。
在現(xiàn)代裝修中,無論是居家場所還是公共場所,墻面和天花在空間內(nèi)占比大,那么在裝飾裝修時應(yīng)盡可能地選擇有機物含量極低、抑菌抗菌效果極好的墻面涂裝材料,硅藻泥!
為什么要選硅藻泥?
1、硅藻泥的主要成分是硅藻土,硅藻土本身是一種多孔無機礦物,可以吸附空氣中的水分、帶菌粒子,降低環(huán)境中菌含量。
2、硅藻泥的配方大多使用水泥、石灰、石膏等無機凝膠材料為粘合劑,其他填料輔料也是無機材料,產(chǎn)品中幾乎不含給微生物提供營養(yǎng)物質(zhì)的有機物,從而抑制細菌的滋生和繁殖。
3、硅藻泥所使用的無機膠凝材料可使墻面呈堿性,堿性環(huán)境對微生物有一定的抑殺作用。
因此,硅藻泥不僅能有效凈化空氣,還具有很好的抑菌抗菌作用,能大大降低交叉感染的幾率。太氧谷硅藻泥正是這么一種無機物含量極高、抑菌抗菌效果極好的墻面裝飾材料!防霉菌性能和防霉菌耐久性能均達到0級最高級別。


壁紙:壁紙的封閉性和壁紙所使用的有機膠黏材料都使得壁紙墻面極易長霉滋生微生物。
乳膠漆:常用的乳膠漆裝飾涂料,乳液含量越高,封閉性越好,表面易結(jié)露長霉,乳膠漆中含有的乳液、纖維素助劑等大量有機物也是細菌生長的有利環(huán)境。
因此,壁紙和乳膠漆這兩種墻面裝飾材料并不能抑菌抗菌,反而是容易滋生霉菌,受到微生物的侵蝕很容易在表面形成菌斑,不僅大大降低了居住者的生活質(zhì)量,還嚴重危害著人們的健康!
壁紙和乳膠漆的霉菌墻面


太氧谷硅藻泥除了具備抑菌抗菌性能,還具備凈化甲醛、呼吸調(diào)濕、防火阻燃、吸音降噪等等性能。今天主要是針對大家最近廣泛關(guān)注的“新冠肺炎”疫情,詳細展開說明在生活環(huán)境里抑菌抗菌的重要性,理性選擇裝飾裝修材料,科學(xué)防護,拒絕微生物侵害!此外,需注意做好通風和消毒工作喲~
太氧谷硅藻泥始終用心為大家創(chuàng)造健康環(huán)保的居住環(huán)境和提高人們生活環(huán)境的品質(zhì)而努力。
(本文部分內(nèi)容引用原作者:綠色建筑材料國家重點實驗室學(xué)術(shù)帶頭人、中國建筑材料科學(xué)研究總院環(huán)境材料科學(xué)與工程研究所所長 冀志江博士)